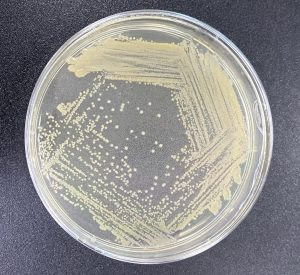

MRSA Infections in Malaysian Healthcare Settings
MRSA Infections in Malaysian Healthcare Settings
By: Mohd Azrul Hisham bin Ismail, Rosniza binti Mohamad Hussain, Nurul Amirah Mohamad Farook, Hui-min Neoh
——
Methicillin-resistant Staphylococcus aureus (MRSA) is a bacteria associated with a wide range of clinical diseases that can range from simple infections such as folliculitis to potentially fatal conditions in healthcare settings such as sepsis (Afatemi & Motamedifar, 2014). The bacteria are Gram-positive, and can be found at various niches on the human body such as axillae, groin, perineal area, nose, mouth, mucus membrane, intestinal, hair, upper respiratory tract, and mammary glands. MRSA can spread in many ways either by water, food, contaminated surface and also direct contact between human and animals (Silva et al., 2021). According to Kim et al., 2025, MRSA infection is increasing in global nosocomial prevalence and remains a “high” priority bacteria in need of antibiotic innovation in the World Health Organization, 2024.
MRSA has been present long time ago since the mid-1970s in Malaysia (Cheong et al., 1994). The earliest study in 1984 found 53 out of 858 babies at Kuala Lumpur Maternity Hospital colonized or infected by MRSA (Lim & Zulkifli, 1987). By 1990, MRSA prevalence was growing in various hospital wards. In the 2000s, studies found that ST239-III has become predominant MRSA clone in Klang Valley area (Ting et al., 2013). Neela et al., 2010 reported ST239-III or IIIa with spa t037 as the dominant clone in 2006. Further investigations confirmed ST239 predominance (Ghaznavi-Rad et al., 2010). This clone showed high resistance to beta-lactam antibiotics (Ting et al., 2013). Around 2010, the proportion of ST22-IV in Malaysian hospitals increased, suggesting a shift in MRSA epidemiology. ST22 clones exhibited high resistance to ciprofloxacin and susceptibility to multiple non-beta-lactam antibiotics. From 2016 to 2017, most MRSA isolates in Kelantan were ST22 (68.2%), followed by ST239 (29.5%) (Alam et al., 2022). By then, SCCmec type IV MRSA was predominant in Malaysia.
We performed MRSA surveillance on the bacteria isolated from Hospital Canselor Tuanku Muhriz (HCTM), the teaching hospital of Universiti Kebangsaan Malaysia (UKM). The first MRSA molecular surveillance at HCTM in 2009 identified SCCmec type III-SCCmercury as the dominant clone. The second surveillance in 2017, involving 222 MRSA strains, revealed a shift to SCCmec type IV, spa type t032, and seg+sei toxin genes. Most strains were resistant to multiple antibiotics (Ismail et al., 2021). Later, genome and phenotype surveillance identify factors associated with this clonal replacement using whole genomic sequencing and phenotypic investigations of HCTM MRSA strains from 2005-2017. Genomic analyses revealed three major MRSA lineages circulating in HCTM: ST239-III, ST22-IV, and ST6-IV. ST239-III strains were more antibiotic-resistant and harbored more AMR genes (Antimicrobial Resistant gene) compared to ST22-IV and ST6-IV. However, ST22-IV and ST6-IV grew faster and were more desiccation-resistant. Reduced antibiotic pressure and higher desiccation tolerance probably gave ST22-IV a competitive edge to become the dominant clone in HCTM from 2017 (Farook et al., 2024). Our investigation highlights the importance of MRSA surveillance and provides baseline genomic data for future studies.
—
SDG 3 | SDG 4
Keywords: Methicillin-resistant-MRSA | Staphylococcus-aureus | Diseases | Health | Wellbeing | Education
More relevant readings: